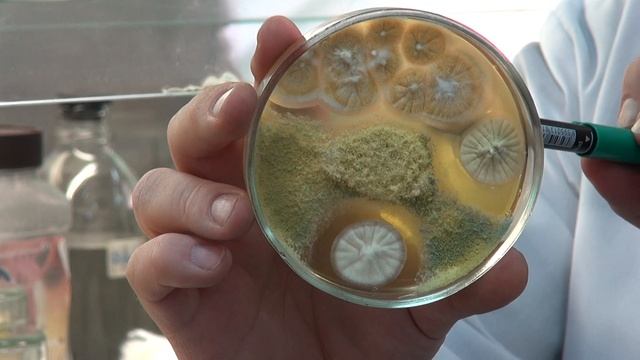
ТРИХОДЕРМА И МЕТАРИЗИУМ || Взаимодействие грибов. Результаты лабораторного опыта. смотреть онлайн

Автор: Строительные Трюки Страница 6

Специальный клей для линолеума LinoleumFix БОЛАРС. Надежная фиксация линолеума

КАК ПОСТАВИТЬ ЛАГЕРЬ В ЛЕСУ, ПОХОДНАЯ ПОЛЕВАЯ КУХНЯ - бушкрафт сушилка, стол, костер, рефлектор

Как построить дачный вариант летнего душа.

Охота на зайца 2020 в заброшенных дачах СССР.

Уход за розами осенью. Обрезка листьев и подкормка!

Дорогами севера. Куст 8А - УПН Южная Приобка

Фотокнига на ксероксе

Не удачный проект складной гладильной доски

Как сохранить Яблоки до весны в идеальном состояние.#яблоки

Сінко де Майо (Cinco de Mayo) яскрава брунатно-червона флорибунда рідкісного кольору

Tanaman untuk Bonsai - Pohon serut laut & Pohon kemuning ( murraya exotica)

-sia- Радиоприемник из Советских времен 50 летней давности издающий странные звуки сигналы, голоса

АРОМАТЫ ДЛЯ ДОМА DIY: ЧЕМ ПАХНЕТ МОЯ КВАРТИРА

SAGA speakers 206. Простая 3х полосная акустика на французских Audax.

Многофункциональная проникающая смазка-спрей VD-60

Ударная дрель-шуруповерт Зубр ЗДА18-ЛИ-КН. Тест на производительность аккумулятора.
ТРИХОДЕРМА И МЕТАРИЗИУМ || Взаимодействие грибов. Результаты лабораторного опыта.

№2. Кроим сваг. Обучение. (.ne, )

Линька у кроликов//Покрытие крольчихи в период линьки

Яблоня обыкновенная Кандиль орловский - Бессемянка мичуринская ? обзор: как сажать, саженцы яблони

Арка Керченского моста,ржавые болты,гавно инструмент, сиз,зарплаты. Украли почти всё. Шарий(34)

РАК. Геракл и лернейская гидра (второй подвиг Геракла). Астрология и мифы

Классическая мебель для гостиной и столовой из массива дуба "Оскар". Белорусская мебель.

Самые живучие птенцы волнистого попугая,жизнь после выпадения из гнезда
За каждым успешным каналом стоит личность, идея и сотни часов кропотливого труда. Если вы здесь, значит, автор «Строительные Трюки» уже сумел зацепить ваше внимание своим уникальным стилем или подачей. А мы на RUVIDEO позаботились о том, чтобы вы могли изучить весь архив его работ в максимально комфортных условиях — без лишней суеты и преград.
Почему за работами канала «Строительные Трюки» так интересно наблюдать? Всё просто: это честный контент, который находит отклик в сердцах зрителей. На нашем ресурсе вы можете смотреть онлайн все видео любимого автора бесплатно и в хорошем качестве. Нам важно, чтобы вы видели каждую деталь и слышали каждый нюанс, поэтому мы используем только стабильные плееры из открытых источников Rutube.
Следите за новинками канала, пересматривайте старые шедевры и открывайте для себя новые грани творчества «Строительные Трюки». Мы постоянно обновляем ленту, чтобы у вас под рукой всегда были самые свежие выпуски. Никаких сложных регистраций — только вы и творчество, которое вдохновляет. Приятного вам путешествия по миру авторского контента на RUVIDEO!
Видео взято из открытых источников Rutube. Если вы правообладатель, обратитесь к первоисточнику.